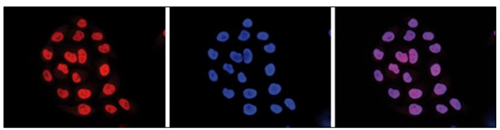
25238.png

PRODUCT CENTER
特色產品本產品是針對在賴氨酸27位點乙酰化的組蛋白H3(H3K27ac)的單克隆抗體,使用KLH偶聯(lián)的合成肽作為免疫原。
作為BPS Bioscience在中國的區(qū)域總代理,艾美捷科技強烈推薦BPS Bioscience熱銷產品Anti-H3K27ac單克隆抗體。產品僅用于科研,不可用于臨床診斷。
| 產品名稱 | 貨號 | 詳情 |
Anti-H3K27ac單克隆抗體 | BPS-25238 | 查看 |
Anti-H3K27ac單克隆抗體:
配方:含有0.05%疊氮化物的PBS緩沖液。
應用:ChIP(每次免疫沉淀1-2 ?g)、ELISA(1:3000)、WB(1:1000 - 1:2000)、IF(1:500)
儲存/穩(wěn)定性:在-80°C下可保存長達2年。首次解凍后離心以最大化產品回收。分裝以避免反復凍融。分裝后可在-20°C下保存至少一個月。
注意事項:避免反復凍融。
備注:每次免疫沉淀的抗體最佳用量應由終端用戶確定。建議測試1-5 ?g/次。
批號:220324
宿主物種:小鼠
濃度:1 ?g/?l
物種反應性:人
規(guī)格:50 ?g
免疫原:合成肽
克隆性:單克隆
純化方法:Protein A純化
產品數(shù)據(jù)庫:
使用針對H3K27ac的單克隆抗體進行免疫熒光實驗。
HeLa細胞用H3K27ac抗體(產品編號25238)和DAPI進行染色。細胞用4%甲醛固定10分鐘,并用含有5%正常山羊血清和1% BSA的PBS/TX-100進行封閉。細胞用H3K27ac抗體(左側)在封閉液中稀釋1:500進行免疫熒光標記,隨后用與Alexa594偶聯(lián)的抗小鼠抗體進行二抗標記。中間圖顯示DAPI對細胞核的染色。右側圖顯示了兩種染色的合并圖像。
BPS Bioscience是一家通過ISO 9001:2015認證的生命科學領域的供應商,公司一直致力于開發(fā)藥物研發(fā)領域的重組蛋白酶、蛋白酶活性/抑制劑篩選試劑盒和慢病毒等工具。公司由Henry Zhu博士于2005年創(chuàng)立,從創(chuàng)立至今一直致力于提供藥物研發(fā)領域的創(chuàng)新解決方案,以推動新的藥物發(fā)現(xiàn)a。公司主要關注的領域包括免疫療法、表觀遺傳學、新型冠狀病毒、CRISPR、細胞信號轉導等,主要提供激酶、磷酸二酯酶、磷酸酶、組蛋白去甲基化酶、組蛋白甲基化轉移酶、HDACs、聚ADP核糖聚合酶等。
作為BPS Bioscience在中國的區(qū)域代理,艾美捷科技有限公司將為中國客戶提供全面的BPS Bioscience以及客戶訂制化服務。


微信掃碼在線客服